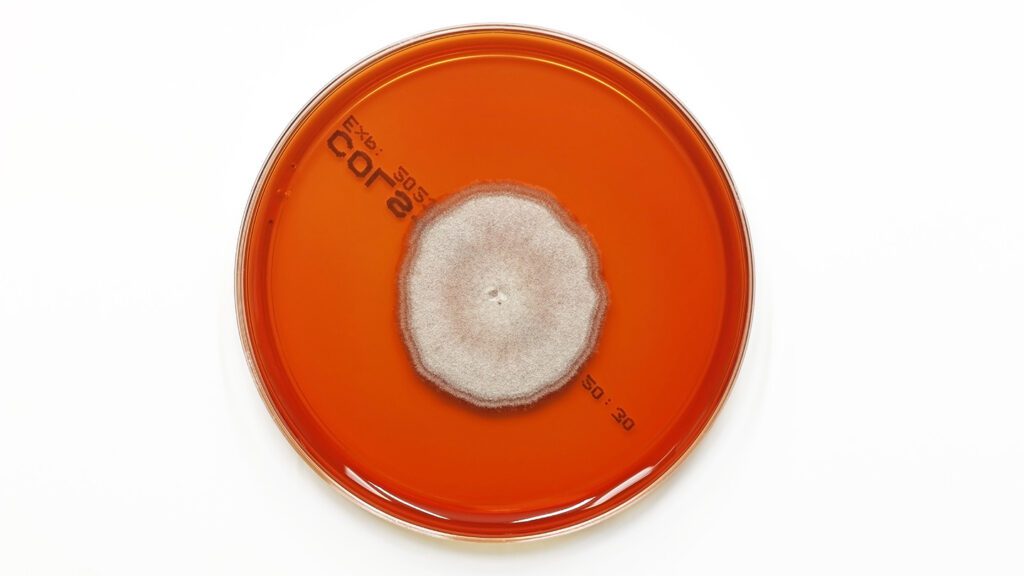
A new antifungal drug works in a surprising way 032425 ts new antifungal feat.jpg

A newly discovered bacterial weapon against fungi can kill even drug-resistant strains, raising hopes for a new antifungal drug.
Fungal infections have been spreading rapidly and widely in recent years, fueled in part by climate change. Some fungi, including Candida auris, have developed resistance to some highly effective antifungal drugs which have been in use for decades. So scientists have been searching for new drugs to keep fungi in check.
Researchers in China may have found a new type of antifungal called mandimycin, the team reports March 19 in Nature. Mandimycin killed fungal infections in mice more effectively than amphotericin B and several other commonly used antifungal drugs. It even worked against resistant C. auris strains.
Bacteria are masters at fending off fungi, says Martin Burke, a chemist at the University of Illinois Urbana-Champaign. “There’s been this war raging for 2 billion years,” he says. Bacteria and fungi have been “building weapons to try to compete with each other for nutrients in the environment.” Humans have been spying on both armies to learn how to make antibiotics and antifungal drugs.
In one such mission, Zongqiang Wang of China Pharmaceutical University in Nanjing and colleagues combed more than 300,000 bacterial genomes looking for possible weapons against fungi. One strain of Streptomyces netropsis contained a cluster of genes that encode enzymes for building the compound mandimycin.
The antifungal has a backbone structure similar to some other antifungal drugs but has two sugar molecules tacked onto its tail. Those sugars are important for how the molecule kills fungi, because they change the target that the weapon is aimed at.
Some existing antifungal drugs like amphotericin B clump together to form large spongelike structures on fungi’s cell membranes, Burke and colleagues previously found. This antifungal sponge pulls a molecule called ergosterol from the membrane faster than the fungi can make more. Ergosterol helps maintain fungal membranes’ stability, crucial for protecting a cell’s inner workings. Extracting this membrane component eventually kills the fungus. Though it’s good at killing fungi, amphotericin B has drawbacks. It can also extract cholesterol from human cells, making it toxic to kidneys.
Mandimycin may also be a sponge, Burke and Arun Maji of the University of Kentucky College of Pharmacy in Lexington speculate in a commentary also published March 19 in Nature, but it sops up different membrane components.
Instead of ergosterol, mandimycin is attracted to phospholipids, the major building blocks of membranes, Wang and colleagues discovered. It’s the sugars on the tail that allow mandimycin to target phospholipids, particularly one called phosphatidylinositol, the team found. Removing those sugars caused mandimycin to latch on to ergosterol, though more weakly than existing antifungals.
While intact mandimycin proved to be a potent fungi killer, it was far less toxic to mice’s kidneys and to human kidney cells grown in lab dishes than amphotericin B. Bacteria escaped mandimycin unscathed.
The ability to destroy fungi but not harm human and bacterial cells has Burke puzzled.
“This is the wild part about mandimycin that I don’t understand,” he says. Why doesn’t it kill the bacteria that produce it?
Only fungi have ergosterol in their membranes, so other cells aren’t harmed by drugs that soak it up. But fungi, bacteria and mammals all have phospholipids, which means pulling those out of membranes should be damaging across the board, including to the mandimycin-making bacteria. Wang and colleagues suggest that mandimycin’s attacks might be specific to phospholipids found in fungi, but not in other types of cells.
That is just one of the mysteries researchers will need to solve before mandimycin can be tested in people, Burke says. “It’s one of those exciting papers that opens a lot of doors, [and] pretty much behind every one is another question.”